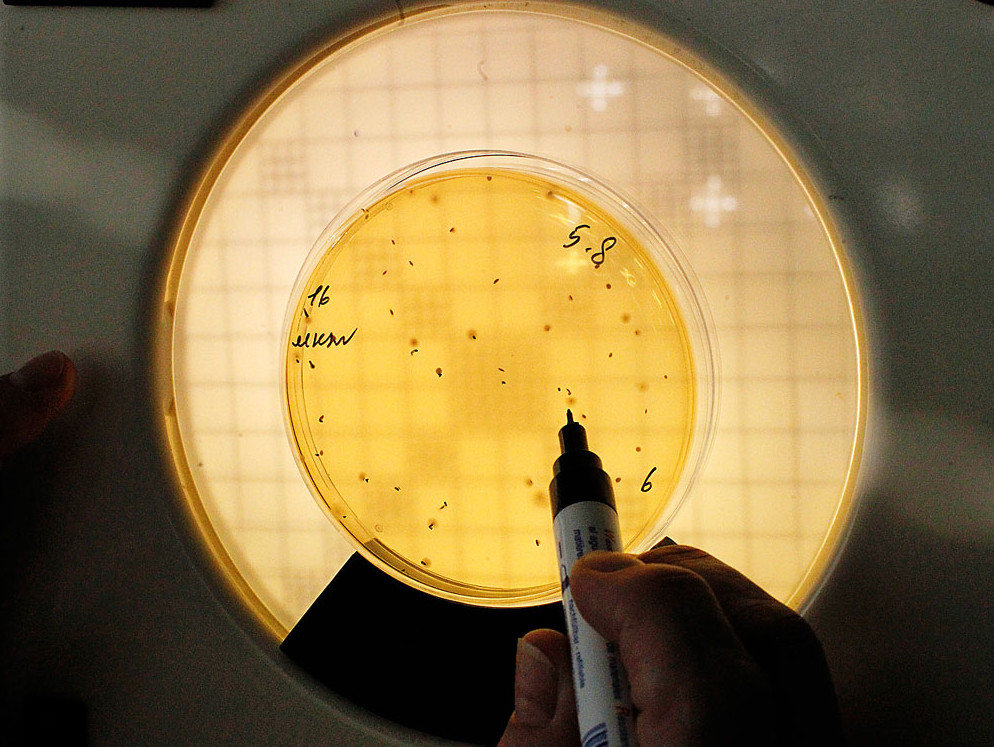

Умри все живое: мифы и правда о пастеризованном молоке
Высокие температуры, давление под 6000 атмосфер, ионизирующая радиация — каким только пыткам не подвергается молоко, перед тем как попасть на прилавки. И все эти ухищрения лишь для того, чтобы сохранить натуральный продукт в первозданном виде.

Каждый день миллионы городских жителей, которые видели коров разве что на картинках, без всякой опаски пьют свежее молоко. Между тем полтора столетия назад такое было совершенно немыслимо: срок хранения парного молока составлял считаные часы, поэтому довезти его до города удавалось далеко не всегда — по дороге оно скисало, а то и вовсе становилось опасным для жизни.
Молоко любят не только млекопитающие, к классу которых относится и человек. Это отличная питательная среда для различных микроорганизмов. Самые распространенные из них — «добрые» молочнокислые бактерии, превращающие молоко в простоквашу и творог. Однако в молоке порой скрываются тихие убийцы: возбудители туберкулеза, бруцеллеза, дифтерии, скарлатины, а также другие патогены — сальмонеллы, листерии, иерсинии, кампилобактерии, золотистый стафилококк, кишечная палочка. Микробы могут попасть в молоко из организма коров, овец или коз, с их кожи, из окружающей среды, их способны занести насекомые или грызуны.
Благодетель человечества
Еще в начале XX века это было серьезной проблемой. Согласно данным, опубликованным в Британском медицинском журнале, с 1912 по 1937 год только в Англии более 2,5 тысячи человек ежегодно умирали от туберкулеза после употребления сырого молока. Однако пастеризация, позволившая спасти человечество от этой напасти, была изобретена совсем для другого продукта.

Французский химик и микробиолог Луи Пастер, именем которого назвали этот процесс, заслужил звание «Благодетель человечества». В 1865 году он запатентовал технологию нагревания до умеренной температуры (примерно до 60 градусов Цельсия) без доступа воздуха… вина. С помощью своего изобретения ученый решил проблему государственного масштаба. После подписания англо-французского соглашения о свободной торговле англичане стали с радостью скупать французские вина, но вскоре обнаружили, что значительная доля продукции страдала неведомой «болезнью»: вместо вина в бутылках оказывался уксус. По поручению Наполеона III Пастер взялся найти выход из положения и добился успеха. Пастеризация стала широко применяться для обработки не только вина, но и пива, а позднее и других пищевых продуктов.
Чтобы по достоинству оценить заслуги изобретателя, нужно учесть: в биологии XIX века господствовала теория самозарождения, согласно которой микроорганизмы при благоприятных условиях появлялись сами собой из ничего. Именно Пастер показал, что от микробов можно избавиться раз и навсегда, ибо в продукты они попадают из окружающей среды. Помимо прочего, ученые тех времен ничего не знали о ферментации, считая процесс брожения чисто химическим. Луи Пастер доказал, что всю работу по превращению сахара в спирт выполняют живые существа — дрожжи.
